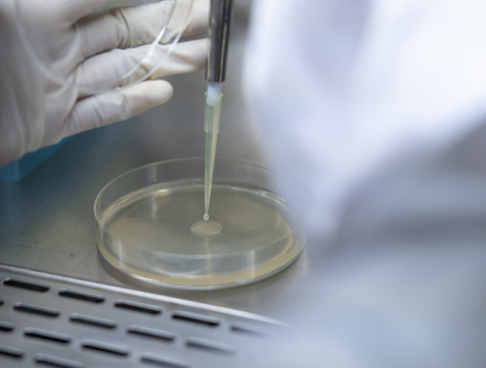

El cultivo microbiológico es una de las técnicas fundamentales en el laboratorio, utilizada para estudiar microorganismos como bacterias, hongos y levaduras. Gracias a este procedimiento, es posible identificar agentes patógenos, analizar su comportamiento y determinar tratamientos adecuados en áreas como la medicina, la microbiología y la industria alimentaria.
Aunque a simple vista puede parecer un proceso rutinario, un cultivo microbiológico requiere precisión, condiciones controladas y un manejo adecuado de los materiales para evitar errores que comprometan los resultados.
En esta guía completa aprenderás qué es un cultivo microbiológico, cómo se realiza paso a paso, los tipos de medios de cultivo y los errores más comunes que debes evitar.
¿Qué es un cultivo microbiológico?
Un cultivo microbiológico es una técnica de laboratorio que consiste en hacer crecer microorganismos en un medio nutritivo bajo condiciones controladas, con el fin de estudiarlos o identificarlos.
Estos microorganismos pueden provenir de muestras clínicas (sangre, orina, tejido), ambientales o alimentarias.
El objetivo principal es permitir que los microorganismos se multipliquen hasta ser visibles y analizables.
¿Para qué sirve un cultivo microbiológico?
Los cultivos microbiológicos tienen múltiples aplicaciones:
- Diagnóstico de infecciones
- Identificación de bacterias y hongos
- Pruebas de sensibilidad a antibióticos
- Control de calidad en alimentos
- Investigación científica
Son esenciales para tomar decisiones clínicas y garantizar la seguridad sanitaria.
Procedimiento paso a paso de un cultivo microbiológico
Realizar un cultivo microbiológico correctamente requiere seguir un protocolo riguroso.
1. Toma de muestra
Todo comienza con la recolección adecuada de la muestra.
Ejemplos de muestras:
- Sangre
- Orina
- Secreciones
- Tejidos
- Alimentos
Es fundamental evitar la contaminación desde este primer paso.
2. Preparación del medio de cultivo
El medio de cultivo es el ambiente donde crecerán los microorganismos.
Puede presentarse en forma líquida, sólida o semisólida.
Debe contener nutrientes esenciales como:
- Agua
- Sales minerales
- Fuente de carbono
- Fuente de energía
3. Inoculación
Consiste en transferir la muestra al medio de cultivo.
Se realiza con instrumentos estériles como:
- Asa bacteriológica
- Pipetas
- Hisopos
Este paso debe hacerse en condiciones asépticas para evitar contaminación.
4. Incubación
El medio inoculado se coloca en una incubadora a temperatura controlada.
Condiciones comunes:
- 35–37 °C para bacterias humanas
- Tiempo: 24 a 72 horas (o más, según el microorganismo)
Durante este tiempo, los microorganismos se multiplican.
5. Observación y análisis
Una vez incubado, se examina el crecimiento.
Se analizan aspectos como:
- Forma de las colonias
- Color
- Tamaño
- Textura
Estos parámetros ayudan a identificar el microorganismo.
6. Pruebas complementarias
Para confirmar la identificación, se pueden realizar:
- Tinciones (como Gram)
- Pruebas bioquímicas
- Antibiogramas
Esto permite determinar el tratamiento más adecuado en contextos clínicos.
Tipos de medios de cultivo
Los medios de cultivo son clave en el éxito del cultivo microbiológico. Se clasifican según su composición y función.
1. Medios de cultivo nutritivos
Contienen los nutrientes básicos para el crecimiento de microorganismos no exigentes.
Ejemplo:
- Agar nutritivo
Se utilizan para cultivo general.
2. Medios selectivos
Favorecen el crecimiento de ciertos microorganismos e inhiben otros.
Ejemplo:
- Agar MacConkey
Ideal para aislar bacterias específicas.
3. Medios diferenciales
Permiten distinguir microorganismos según sus características bioquímicas.
Cambian de color según la reacción del microorganismo.
4. Medios enriquecidos
Contienen nutrientes adicionales para microorganismos exigentes.
Ejemplo:
- Agar sangre
Se utilizan en muestras clínicas complejas.
5. Medios líquidos
No contienen agente solidificante.
Se usan para aumentar rápidamente la cantidad de microorganismos.
Errores frecuentes en el cultivo microbiológico
Incluso pequeños descuidos pueden arruinar un cultivo.
1. Contaminación de la muestra
Es uno de los errores más comunes.
Puede ocurrir por:
- Falta de esterilización
- Manipulación incorrecta
- Ambiente no controlado
2. Uso incorrecto del medio de cultivo
Elegir un medio inadecuado puede impedir el crecimiento del microorganismo.
3. Condiciones de incubación inadecuadas
Temperatura o tiempo incorrectos afectan directamente el resultado.
4. Técnica aséptica deficiente
No seguir protocolos de esterilidad puede introducir microorganismos externos.
5. Interpretación incorrecta
Confundir colonias o no realizar pruebas complementarias puede llevar a diagnósticos erróneos.
Importancia de la técnica aséptica
La técnica aséptica es esencial en todo el proceso.
Incluye prácticas como:
- Esterilizar instrumentos
- Trabajar cerca de una llama o en cabina de flujo laminar
- Evitar corrientes de aire
- Utilizar guantes y material estéril
Sin estas medidas, los resultados pierden validez.
Aplicaciones del cultivo microbiológico en la vida real
El cultivo microbiológico no solo se utiliza en hospitales.
También tiene aplicaciones en:
- Industria alimentaria (control de calidad)
- Investigación científica
- Producción farmacéutica
- Control ambiental
Es una herramienta clave en múltiples sectores.
El cultivo microbiológico es una técnica esencial para el estudio de microorganismos y el diagnóstico de enfermedades. Aunque su procedimiento puede parecer sencillo, requiere precisión, conocimiento y disciplina en cada etapa.
Desde la elección del medio de cultivo hasta la interpretación final, cada paso influye en la calidad del resultado.
Dominar esta técnica no solo mejora la práctica en laboratorio, sino que también contribuye directamente a la salud pública, la investigación y el avance científico.